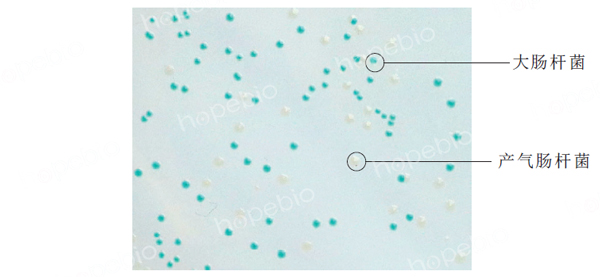

海博微信公众号
海博微信公众号
 海博天猫旗舰店
海博天猫旗舰店


 海博微信公众号
海博微信公众号
 海博天猫旗舰店
海博天猫旗舰店




一、培养基用途及原理简介
胰蛋白胨胆盐X-葡萄糖醛酸苷琼脂(TBX)在2025版GB4789.38标准中替代了旧版的VRBA-MUG培养基,用于大肠埃希氏菌的计数培养及鉴定。培养基中的胰蛋白胨提供细菌生长的基本营养,胆盐对大多数革兰氏阳性菌具有较强的抑制效果,琼脂为凝固剂,5-溴-4-氯-3-吲哚-β-D-葡萄糖醛酸苷(BCIG)为特异性显色剂,用于检测β-葡萄糖醛酸苷酶的活性,大肠埃希氏菌可产生β-葡萄糖醛酸苷酶,分解BCIG生成深蓝色化合物,菌落变为蓝色或蓝绿色。
二、成分(g/L)
|
胰蛋白胨 3号胆盐 5-溴-4-氯-3-吲哚-β-D-葡萄糖醛酸苷(BCIG)环己胺盐或钠盐 琼脂 |
20.0 1.5 144μmol 9-18 |
|
pH |
7.2±0.2 |
三、使用方法及生长现象
称取本品36.6g,加入1000ml蒸馏水,加热溶解并不停搅拌,煮沸不要超过1分钟。分装三角瓶,121℃高压灭菌15分钟。取1ml制备好的样品液加入直径为9cm无菌平皿中心,倾入冷却至45-50℃培养基约15ml,混匀,凝固后,36±1℃倒置18~24h。或冷却至45℃-50℃时,倾入无菌平皿,琼脂完全凝固后,在超净工作台中开盖吹15-30分钟,去掉培养基表面水汽,加入适当稀释度的样品液1ml,涂布于培养基上,36±1℃培养18~24h。
接种以下测试菌株,36±1℃培养18-24h。
|
质控菌株 |
菌株编号 |
接种量/CFU |
回收率 |
生长现象 |
|
单增李斯特氏菌 |
ATCC19114 |
100-1000 |
/ |
部分或完全抑制 |
|
金黄色葡萄球菌 |
ATCC25923 |
100-1000 |
/ |
部分或完全抑制 |
|
大肠埃希氏菌 |
ATCC25922 |
10-100 |
≥70% |
蓝色或蓝绿色菌落 |
|
鼠伤寒沙门氏菌 |
ATCC14028 |
10-100 |
≥70% |
无色菌落 |
|
阴沟肠杆菌 |
ATCC23355 |
10-100 |
≥70% |
无色菌落 |
|
产气肠杆菌 |
ATCC35029 |
10-100 |
≥70% |
无色菌落 |
四、假阳性及假阴性结果分析
1.假阳性:由于肠杆菌科中个别沙门氏菌、志贺氏菌也具有β-葡萄糖醛酸苷酶活性,也能在TBX琼脂上生长为蓝绿色菌落,造成假阳性结果,但可以通过乳糖发酵试验进行排除,大肠埃希氏菌可在44.5℃发酵乳糖产酸产气,沙门氏菌、志贺氏菌则不能。另外还有部分革兰氏阳性菌也会有β葡萄糖醛酸苷酶活性,但由于生长受到胆盐抑制,在TBX培养基上不能生长或者生长缓慢,在24h内一般不显色或显色很浅。
2.假阴性:部分致泻大肠埃希氏菌不具有编码β-葡萄糖醛酸苷酶的基因或虽有该基因但无表达活性(如O157致泻大肠埃希氏菌),在TBX培养基上菌落不显蓝绿色。还有部分大肠埃希氏菌虽然具有β-葡萄糖醛酸苷酶基因,但表达活性弱,在24h内通常不易观察到蓝绿色,在24-48h或更长时间后菌落才会逐渐出现蓝绿色反应。
相关产品:
胰蛋白胨胆盐X-葡萄糖醛酸苷(TBX)琼脂(干粉)-点击查看产品详情
注:本文属海博生物原创,未经允许不得转载。
上一篇:肉汤琼脂培养基的原理及使用方法
| 相关文章: | ||



